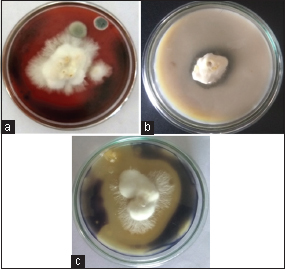

1. INTRODUCTION
Macrofungi of oyster mushroom (Pleurotus florida) have the capability to produce a high variety of intracellular and extracellular enzymes which can degrade agro-waste materials contain complex organic compounds into simple low molecular weight compounds. These are water soluble and remarkable nutritive value [1]. The enzymes secreted from mushrooms are nonspecific, and it can decompose a wide variety of structurally different compounds [2]. Basically mushroom like basidiomycetes of fungal cell does not have chlorophyll like plants, so it cannot produce their own food using carbon dioxide, mineral ions, and water for photosynthesis as do green plants. Mushrooms are heterotrophs and obtain their nutrients by absorbing soluble inorganic and organic materials from agro substrates such as wood logs, manure composts, or other organic synthetic composts.
Approximately two million tons of spent mushroom compost waste are produced yearly by mushroom farms, with almost 1.2 million tons generated from oyster mushrooms. This high amount of spent mushroom compost waste is incompatible for reuse in mushroom production; therefore, it is used either as garden fertilizer or deposited in landfills, which pollutes the environment. Spent oyster mushroom (P. florida) compost wastes contain fungal mycelia, extracellular enzymes, and unused lignocellulosic compounds [3]. The waste from oyster mushroom farms has been used in novel processes such as production of value-added products such as biogas production, bulk enzyme extraction, and production of organic fertilizer; animal feed supplements and used in degradation of pentachlorophenol [4-6]. The utilization of oyster mushroom compost waste is benefit for human health and the environment because the agricultural waste from mushroom farms used as raw materials for various processes.
The current investigation was performed to isolate and partial purification of the various industrial enzyme from oyster mushroom (P. florida) compost waste, which is utilized in various environmental applications such as starch hydrolysis of potato waste and biotreatment of cotton waste.
2. MATERIALS AND METHODS
2.1. Mushroom Bed Preparation
Oyster mushroom (P. florida) bed was prepared using rice straw waste from agro-industry in Tiruchengode, Namakkal (Dt) in Tamil Nadu. The autoclavable polypropylene bags containing layers of rice straw were inoculated with P. florida mushroom spawn, which was incubated at 25 ± 28°C for 25 days in darkroom. After 25 days of incubation, the mycelia were fully covered in whole bed and produce mushroom flushes. After third or fourth yield, old mushroom bed was used as a source for crude industrial enzyme extraction.
2.2. Plate Assay for Various Enzymes
Oyster mushroom (P. florida) was screened for various industrial enzymes using agar plate method with the following compositions.
2.2.1. Amylase test
Oyster mushroom (P. florida) mycelia stage was tested for amylase production by starch hydrolysis. Starch agar medium contains peptone, 5 g; beef extract, 3 g; starch, 20 g; agar, 15 g; and distilled water, 1000 ml, which was inoculated with oyster mushroom (P. florida) mycelia stage and incubated at 28°C for 8 days. After 8 days of incubation, the mycelial growth containing agar plate was flooded with iodine solution. After 1 day of incubation, the clear zone around mycelia indicated the production of amylase [7].
2.2.2. Carboxymethyl cellulose (CMC) agar medium for cellulase test
Cellulase enzyme production from mycelia stage of P. florida was tested using CMC agar medium. In this media contain malt extract, 20 g/l; agar, 15 g/l; carboxymethyl cellulose sodium salt, and 10 g/l mycelia stage of P. florida were inoculated in CMC agar plate and incubated at 28°C for 8 days. After 8 days of incubation, the plates were flooded with 0.2% of aqueous Congo Red Solution, then which was destained with 1 M NaCl for 15 min. The appearance of yellow areas around the mycelia indicates the presence of cellulase activity [8].
2.2.3. Gelatin agar medium for protease test
For protease test, the P. florida mycelia were inoculated on casein agar medium (g/l) (gelatin, 20; casein, 10; sodium chloride, 10; sodium bicarbonate, 1; and agar 15) and incubated at 28°C for 8 days. The presence of protease activity was determined by protease agar plate flooded with mercuric chloride solution (20% HCl was mixed in 15% mercuric chloride solution). The presence of clear zone surrounding the mushroom mycelia indicates protease activity [9].
2.3. Collection of Oyster Mushroom (P. florida) Compost Waste
The oyster mushroom (P. florida) compost waste was collected from Mushroom farm, Vivekanandha College of Engineering for Women, Tiruchengode, Namakkal (Dt) in Tamil Nadu.
2.4. Preparation of Crude Enzyme Extract
The oyster mushroom (P. florida) compost waste (25 g, ~75–85% moisture) was taken and homogenized using mortar and pestle in 250 ml of 50 mM sodium acetate buffer, pH 5.4, and filter through muslin cloth. The filtrate was clarified by centrifugation at 4000 rpm for 15 min. The obtained supernatant was used for further studies [10].
2.5. Protein Estimation
The total protein content of crude enzyme extract from oyster mushroom (P. florida) compost waste was determined by Lowry’s method. To 1000 μl of the sample, 4.5 ml of alkaline copper sulfate reagent was added, mixed well and allowed to stand at room temperature for 10 min, then 0.5 ml of diluted Folin–Ciocalteu’s phenol reagent was added, and after 30 min of incubation at room temperature, absorbance was measured at 660 nm. The protein content in sample was calculated from a standard curve prepared with bovine serum albumin as a standard [11].
2.6. Estimation of Enzyme Activities
2.6.1. Amylase assay
Amylase activity was measured by estimation of reducing sugar released from starch. In this assay, a volume of 1 ml of the crude enzyme extract was incubated with 1 ml of 1% starch solution (pH 6.9) at 30°C for 30 min. Then, 1 ml DNS reagent was added into the reaction mixture, which was kept in a boiling water bath for 10 min. After 10 min incubation, the solution was cooled at room temperature, and the optical density of reaction mixture was read at 540 nm [12].
2.6.2. Cellulase assay
Cellulase activity was assayed using cellulose as the substrate. In this assay, cellulose was dissolved in 10% NaOH at a cold temperature (4°C). 1 ml of crude enzyme extract was incubated in 1 ml of dissolved cellulose (pH 4.8) at 50°C for 10 min. The activity of reaction mixture was determined using DNS assay method, various concentration of 1% glucose used as a standard for this assay [12].
2.6.3. Protease assay
Protease activity was determined in the crude enzyme extract from P. florida compost waste using 1.5% casein in 0.2 M Tris-HCl buffer, pH 7.2. In this assay, 1 ml of 1.5% casein was added in 1 ml of crude enzyme extract, which was incubated at 37°C for 10 min. 3 ml of 5% TCA was added in the reaction mixture and was incubated at 37°C for 10 min. After 10 min of incubation, the reaction mixture was centrifuged at 10,000 rpm for 10 min, and 0.5 N of NaOH, 0.6 ml of Folin reagents were added and incubated for 30 min, Optical density of reaction mixture was read at 660 nm [13].
2.7. Acetone Precipitation
The enzymes in crude extracts were further precipitated by the gradual addition of chilled 60% (v/v) acetone with continuous stirring and kept in a cold temperature at 4°C for 24 h. The precipitated protein was collected by centrifugation at 12,000 rpm at 4°C for 30 min and dissolved in Tris-HCl buffer (pH 8.0). The sample was dialyzed against the same buffer using acetylated dialysis bag [14].
2.8. Purification of Various Enzymes
The purification of various industrial enzymes was done using a silica gel chromatography column. This was equilibrated with 50 mM potassium phosphate buffer (Buffer A-pH 7). The presence of dialyzed enzyme solution (30 μl) in the column was washed with 4 ml of Buffer A. Elution was done by distilled water. The active fractions of different enzymes such as cellulase, amylase, and protease were detected at 540 nm, 420 nm, and 660 nm, respectively.
2.9. Storage Stability of Crude Enzymes
The storage stability of crude industrial enzymes was analyzed using 1 ml of crude extract and was mixed with 1 ml of 50 mM sodium acetate buffer (pH 5.8) and stored at 4°C. The crude enzymes activity were analyzed every day up to 5 days.
2.10. Application Studies
2.10.1. Starch processing of potato waste
Potato (59 g) was homogenized using distilled water, which was treated with 100 ml of crude enzyme extract from P. florida compost waste. One flask containing potato homogenate with the addition of 100 ml distilled water was act as control. The starch degrading capability of crude enzyme extract was analyzed using dinitrosalicylic acid method [12].
2.10.2. Biotreatment of cotton waste
Cotton waste (1.5 g) was treated with 100 ml of crude enzyme extract from oyster mushroom (P. florida) compost waste in non-agitated and agitated systems at pH 5.8 (50 mM Sodium acetate buffer). The flask was incubated at 37°C for 24 h. After enzymatic treatment, the cotton waste was washed twice in hot distilled water to deactivate the enzyme and then air-dried.
Weight loss of cotton waste from crude enzymatic treatment was determined by weighing the sample before and after the treatment following 24 h of treatment at 37°C. Reducing sugar from the sample was determined by dinitrosalicylic acid method [12]. Enzymatic treated and untreated cotton morphology differences were investigated using light microscope.
3. RESULTS AND DISCUSSION
3.1. Mushroom Bed Preparation
Oyster mushroom (P. florida) bed was prepared using rice straw as substrate. After 25 days of incubation at dark condition, the first stage of mushroom flush was formed. After 3rd and 4th yields, loss of nutrients results in the formation of compost which was used as a substrate for various industrial enzyme extractions.
3.2. Enzymatic Screening of Oyster Mushroom (P. florida) Using Agar Plates
After incubation of various agar plates for 8 days at 28°C for the industrial enzymatic tests, the following results were obtained [Table 1]:
It was seen that the oyster mushroom (P. florida) showed that the best industrial enzymatic activities. Among the three enzymes, the protease enzyme from P. florida was showed less activity.
From these results, the presence of protease activity was determined using mercuric chloride solution. The clear zone around the mushroom mycelia was indicates the protease activity of P. florida [Figure 1a]. The activity of cellulase enzyme from P. florida was analyzed by Congo red aqueous solution. The appearance of yellow areas around the mycelia indicates the presence of cellulase activity [Figure 1b]. The iodine solution was used to detect the amylase enzyme activity from P. florida. Clear zone around the mushroom mycelia indicates the presence of amylase activity [Figure 1c].
Many reports suggested that the secretions of industrial enzymes in mushrooms are used for its fruiting body formation [15]. Reports from Slawinska and Kalbarczyk 2011 show that the cellulase enzyme activity in some Pleurotus species is more than the amylase activity; hence, the same result was recorded in the current study [16]. Protease enzyme from various fungal sources is important in pharmaceutical industries for various medical applications [17].
3.3. Quantification of Enzymes
Oyster mushroom (P. florida) compost waste contains lot of industrially important enzymes such as amylase, cellulase, and protease [Figure 2]. Among the three enzymes, activity of cellulase was found to be higher than other enzymes and found to be 15.78 U/ml, respectively. Amylase enzyme activity from crude extract of P. florida compost waste was 3.42 U/ml. The activity of protease enzyme from crude extract of compost waste was 0.042 U/ml. From this result, the oyster mushroom (P. florida) compost waste as a good source for extraction of lot industrially important enzymes.
Similar to this observation, the waste produced from oyster mushroom forms for extraction of industrially important enzymes that have previously been studied [18]. The reutilization of oyster mushroom compost waste was reduce a lot of environmental problems such as disposals of bulk density of waste into the soil, stability, surface crust, temperature changes, pH changes in soil, aeration, and water retention capacity of soil [19]. Many investigations reported that the spent oyster mushroom compost has a plenty of extracellular enzymes. The highest specific activity of cellulase (19.2 U/mg) was obtained using 50 mM sodium acetate (pH 5.8) extraction buffer. Low specific activity (4.17 U/mg) of amylase enzyme was obtained from P. florida compost waste. Very low specific activity (0.05 U/mg) of protease enzyme was obtained from crude extract. By this study, it was concluded that oyster mushroom (P. florida) compost waste as a good source for extraction of industrially important enzymes [Figure 3].
 | Table 1: Screening of various industrial enzymatic activity of oyster mushroom (Pleurotus florida). [Click here to view] |
| Figure 1: Plate assay for different industrial enzymes (a) plate test for cellulase, (b) plate test for protease, and (c) plate test for amylase [Click here to view] |
 | Figure 2: Total activity of enzymes [Click here to view] |
3.4. Storage Stability Test for Industrial Enzymes
From this study, the storage stability of crude amylase enzyme from oyster mushroom (P. florida) compost waste was decreased after 5 days of incubation at 4°C in pH 5.6 [Figure 4].
3.5. Purification of Different Enzymes
Figure 5 shows the result of each step of different enzymes purification. Activities of purified enzymes using gel filtration chromatography were cellulase (7.65 U/ml), amylase (0.45 U/ml), and protease (0.001 U/ml), respectively [Figure 5].
3.6. Biotreatment of Cotton Waste
From this study, the crude enzymatic treatment of cotton waste was evaluated by weight losses of waste cotton before and after treatment. The weight loss value caused by crude enzyme extract from P. florida compost waste is shown in Table 2. The presence cellulase enzyme in the crude extract caused the weight loss (0.1 g) in the cotton waste, after 24 h of incubation.
 | Table 2: Biotreatment of cotton waste. [Click here to view] |
 | Figure 3: Specific activity estimation of enzymes [Click here to view] |
 | Figure 4: Storage stability of industrial enzymes [Click here to view] |
The sample from cotton waste treated with crude cellulase was yield measurable reducing end groups from cotton carbohydrates. Table 2 shows the time dependence of reducing sugar liberation during the crude enzymatic treatment. Csiszar et al., 2001, reported that the amount of released reducing sugar by cellulase and hemicellulase enzymes increases with the time of enzymatic treatment [20]. The present investigation also shows the same result; the reducing sugar production from sample of cotton waste treated with crude enzyme extract from P. florida compost waste was increased based on their increased reaction time.
The morphology changes in the crude enzyme from P. florida compost waste treated cotton sample have been studied with a light microscope. Figure 6 shows the surface morphology of untreated cotton waste from crude enzymatic treated cotton waste. The surface of the crude enzymatic treated cotton sample was varied from untreated cotton sample. During enzymatic treatment the presence of cellulase enzyme in the crude extract causes wall damages in the cotton fiber, which occur due to the presence of cellulose molecules in the primary wall of the cotton. Due to this reaction weight loss of cotton and production of reducing end groups were formed.
3.7. Starch Processing of Potato Waste
In this work investigated that the amylase enzyme from P. florida compost waste extract has potential to degrade starch present in the potato waste. The activity of crude amylase from potato waste containing sample was 0.015 U/ml. This was analyzed by DNS assay method [12]. Many research investigated that crude amylase from various microbes was improves the hydrolyzing of various starches from agro-waste [21-23].
From this study investigates, the crude amylase from P. florida compost waste showed a low level of activity [Table 3]. Hence, the activity of amylase in crude extract was decreased after 3 days of incubation with potato waste.
 | Figure 5: Purification of industrial enzymes [Click here to view] |
 | Figure 6: Morphology analysis (a) cotton without treatment of crude extract, (b) cotton treated by crude extract [Click here to view] |
 | Table 3: Starch processing in potato waste. [Click here to view] |
4. CONCLUSION
The investigation of present work concluded that the oyster mushroom (P. florida) compost waste as a good source for extraction of extracellular industrially important ligninolytic enzymes such as amylase, cellulase, and protease. The enzymatic activity of oyster mushroom P. florida mycelia was screened using different agar media. Higher activities of amylase and cellulase were observed, whereas very less protease activity was observed in mycelial growth on protease agar media. The total protein content of crude extract from compost waste and acetone purified sample was analyzed by Lowry’s method. The protein content of crude sample was 0.82 mg/ml and acetone precipitated sample was 1.25 mg/ml. The activity of crude industrial enzymes from P. florida compost waste extract was analyzed by various quantitative enzyme assay. The crude cellulase enzyme was showed highest activity of 15.78 U/ml, amylase enzyme from crude sample was showed lower activity of 3.42 U/ml. Very low protease activity was shown in crude sample about 0.042 U/ml. The presence cellulase and amylase enzyme in crude extract from P. florida compost waste were utilized in biotreatment of cotton waste and starch hydrolysis in potato waste containing water sample. The desizing of cotton waste was analyzed by weight loss determination, reducing sugar quantification, and microscopic study on morphology analysis of cotton surface. In summary in this work, the various industrial enzymes were extracted from oyster mushroom (P. florida) compost waste and which was utilized diverse environmental applications such as biotreatment of cotton waste and starch hydrolysis in potato waste.
5. REFERENCES
1. Evans CS, Dutton MV, Guillen F, Veness RG. Enzymes and small molecular mass agents with lignocelluloses degradation. FEMS Microbiol Rev 1994;13:235-40. CrossRef
2. Field JA, de JE, Feijoo-Costa G, de BA. Screening for lignolytic fungi applicable to the biodegradation of xenobiotics. Trends Biotechnol 1993;11:44-9. CrossRef
3. Lim SH, Lee YH, Kang HW. Efficient recovery of lignocellulolytic enzymes of spent mushroom compost from oyster mushrooms, Pleurotus spp. and potential use in dye decolorization. Mycobiology 2013;41:214-20. CrossRef
4. Bisaria R, Vasudevan P, Bisaria VS. Utilization of spent agro residues from mushroom cultivation for biogas production. Appl Microbiol Biotechnol 1990;33:607-9. CrossRef
5. Kumaran S, Sastry CA, Vikineswary S. Laccase, cellulase and xylanase activities during growth of Pleurotus sajor-caju on sago hampas. World J Microbiol Biotechnol 1997;13:43-9. CrossRef
6. Vikineswary S, Kumaran KS, Ling SK, Dinesh N, Shim YL. Solid substrate fermentation of agro residues for value added products: The Malaysian experience. In: Wise DL, Editor. Global Environ Biotechnol. Dordrecht: Springer; 1997. p. 301-5. CrossRef
7. Suganthi R, Benazir JF, Santhi R, Kumar VR, Hari A, Meenakshi N, et al. Amylase production by Aspergillus niger under solid state fermentation using agro industrial wastes. Int J Eng Sci Technol 2011;3:1756-63.
8. Khokhar I, Haider MS, Mushtaq S, Mukhtar I. Isolation and screening of highly cellulolytic filamentous fungi. J Appl Sci Environ Manage 2012;16:223-6.
9. Frazier WC. A method for the detection of changes in gelatin due to bacteria. J Infect Dis 1926;39:302-9. CrossRef
10. Rajarathnam S, Wankhede DB, Patwardhan MV. Some chemical and biochemical changes in straw constituents during growth of Pleurotus flabellatus (berk and br) sacc. Eur J Appl Microbiol Biotechnol 1979;8:125-34. CrossRef
11. Lowry OH, Rosebrough NJ, Farr AL, Randall RJ. Protein measurement with the folin phenol reagent. J Biol Chem 1951;193:265-75.
12. Miller GL. Use of dinitrosalicylic acid reagent for determination of reducing sugar. Anal Chem 1959;31:426-8. CrossRef
13. Leighton TJ, Dor RH, Warren RA, Kelln RA. The relationship of serine protease activity to RNA polymerase modification and sporulation in Bacillus subtilis. J Mol Biol 1973;76:103-22. CrossRef
14. Karnchanatat A, Petsom A, Sangvanich P, Piapukiew J, Whalley AJ, Reynolds CD, et al. A novel thermostable endoglucanase from the wood-decaying fungus Daldinia eschscholzii (Ehrenb.:Fr.) Rehm. Enzyme Microb Technol 2008;42:404-13. CrossRef
15. Terashita T, Kono M. Purification and some properties of carboxyl proteinase from Tricholoma matsutake. Trans Mycol Soc Jpn 1989;28:245-56.
16. Slawinska A, Kalbarczyk J. Evaluation of enzymatic activity of Pleurotus ostreatus regarding stages of mycelium development. ACTA Sci Pol Hortoru 2011;10:195-202.
17. Rao MB, Tanksale AM, Ghatge MS, Deshpande VV. Molecular and biotechnological aspects of microbial proteases. Microbiol Mol Biol Rev 1998;62:597-635.
18. Haripriya R, Parkavi V, Jothi D, Delphin DV, Thirumalaivasan P. Industrial important enzymes from spent oyster mushroom bed wastes. World J Pharm Res 2014;3:483-92.
19. Shukry WM, El-Fallal AA, El-Bassiouny HM. Effect of spent wheat straw growth, growth hormones, metabolism and rhizosphere of Cucumis sativa. Egypt Soc Physiol Sci 1999;23:39-69.
20. Csiszar E, Urbanszki K, Szakacs G. Biotreatment of desized cotton fabric by commercial cellulase and xylanase enzymes. J Mol Catal B Enzym 2001;11:1065-72. CrossRef
21. Shukla RJ, Singh SP. Characteristics and Thermodynamics of α-amylase from Thermophilic actinobacterium, Laceyella sacchari TSI-2. Process Biochem 2015;50:2128-36. CrossRef
22. Dhingra S, Khanna M, Pundir CS. Immobilization of α-amylase on to alkylamine glass beads affixed inside a plastic beaker: kinetic properties and application. Indian J Chem Technol 2006;13:34-40.
23. Prakash O, Jaiswal N. Immobilization of a thermostable α-amylase on agrose and agar matrics and its application in starch stain removal. World Appl Sci J 2011;13:572-7.